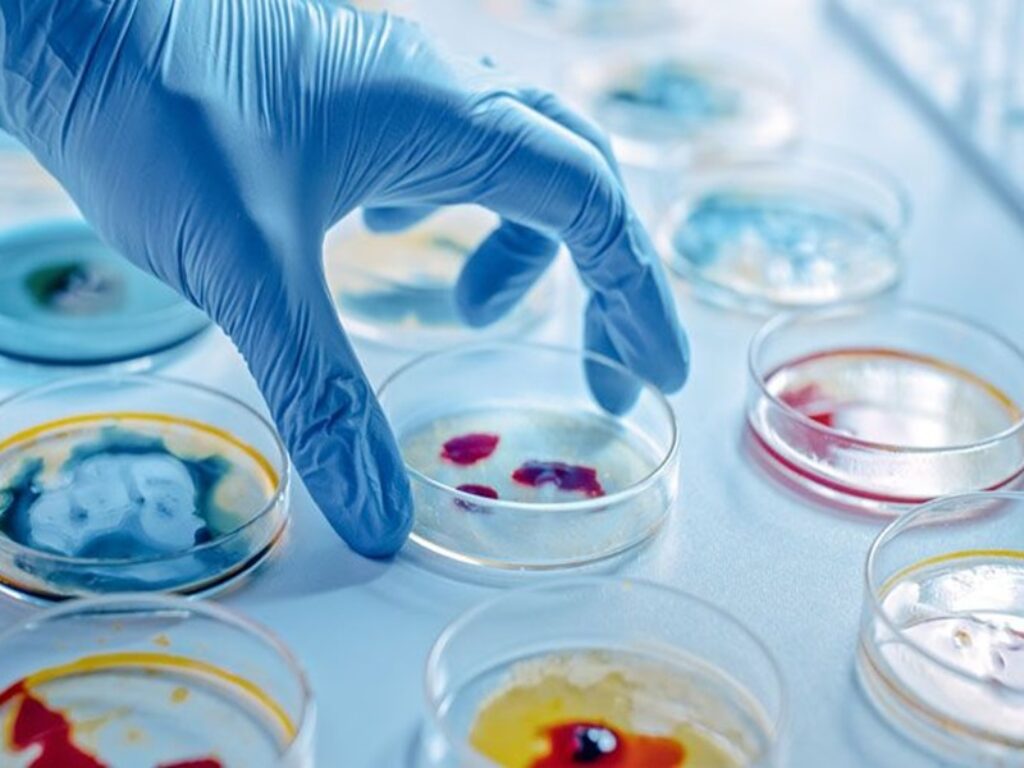

Elevata efficacia di cefiderocol nella sopravvivenza al 28° giorno nel trattamento delle infezioni da patogeni Gram-negativi, con opzioni terapeutiche limitate
Sono stati presentati durante il 34° Congresso europeo di Microbiologia Clinica e Malattie Infettive (ESCMID Global 2024) degli importanti dati, tratti dallo Studio Perseus, il più ampio trial europeo di real-world evidence, che evidenziano un’elevata efficacia di cefiderocol nella sopravvivenza al 28° giorno nel trattamento delle infezioni da patogeni Gram-negativi, con opzioni terapeutiche limitate, in prevalenza rappresentate da P. aeruginosa.
Cefiderocol è una cefalosporina siderofora di ultima generazione, impiegata nel trattamento delle infezioni batteriche da patogeni Gram-negativi resistenti ai carbapenemi in pazienti in condizioni critiche.
Perseus è uno studio osservazionale retrospettivo multicentrico che valuta l’efficacia e la sicurezza in real-world di cefiderocol in pazienti adulti con infezioni batteriche causate da germi Gram-negativi.
L’analisi ha rilevato che i pazienti trattati con cefiderocol mostrano complessivamente una elevata percentuale di successo clinico (endpoint primario composito definito come la guarigione clinica e/o la sopravvivenza al giorno 28 del 78,5%) dell’84,3%, e una mortalità per tutte le cause del 21,5%.
La maggior parte dei pazienti aveva infezioni del tratto respiratorio (47,9%) causate principalmente da Pseudomonas aeruginosa (66.7%), Klebsiella pneumoniae (10.0%) e Stenotrophomonas maltophilia (7.7%). Inoltre, il 19,5% presentava infezioni polimicrobiche.
Lo studio ha incluso 261 pazienti adulti in condizioni critiche con opzioni terapeutiche limitate trattati con cefiderocol per non più di 28 giorni nell’ambito del programma Early Access di Shionogi in Spagna. Di questi, il 64,8% era resistente a tutti gli antibiotici testati e il 44,4% aveva avuto un fallimento terapeutico con antibiotici utilizzati precedentemente.
I pazienti hanno ricevuto cefiderocol per ≥72 ore consecutive dopo la diagnosi confermata di infezione batterica da germi Gram-negativi. I pazienti inclusi nell’analisi erano in condizioni critiche, con quasi due terzi (63,2%) in terapia intensiva, il 47,1% in ventilazione meccanica e il 28% in shock settico.
In questi 261 pazienti, cefiderocol è stato generalmente ben tollerato, con sei pazienti che hanno presentato una reazione avversa al farmaco.
“La crescente resistenza delle infezioni batteriche da germi Gram-negativi alle terapie attuali ne rende difficile il trattamento – dichiara il prof. Carlo Tascini, Direttore della Clinica di Malattie Infettive dell’Università di Udine – Le evidenze cliniche in real-world risultano particolarmente rilevanti quando si studia l’uso degli antibiotici nei confronti di patogeni multiresistenti ai farmaci, a causa delle difficoltà di condurre studi clinici randomizzati. Questi nuovi dati rafforzano l’importanza di cefiderocol e contribuiscono al numero crescente di evidenze real-world nel trattamento dei pazienti con infezioni da patogeni difficili da trattare e resistenti ad altri antibiotici in particolare nel contesto delle infezioni da P. aeruginosa.”
“Shionogi è impegnata da 60 anni nello sviluppo di farmaci antinfettivi e nel contrasto alla crescente minaccia dell’antibiotico-resistenza, una delle sfide riconosciute come prioritarie per la sanità pubblica – dichiara Simona Falciai, General Manager di Shionogi Italia – Cefiderocol è incluso nell’elenco dei farmaci essenziali dell’Organizzazione Mondiale della Sanità e in Italia è il primo antibiotico a aver ricevuto dall’Aifa la designazione di farmaco innovativo in forma piena. I dati appena presentati al Congresso ESCMID confermano il suo importante valore terapeutico nel trattamento di quelle infezioni che ad oggi hanno ancora limitate opzioni di cura.”